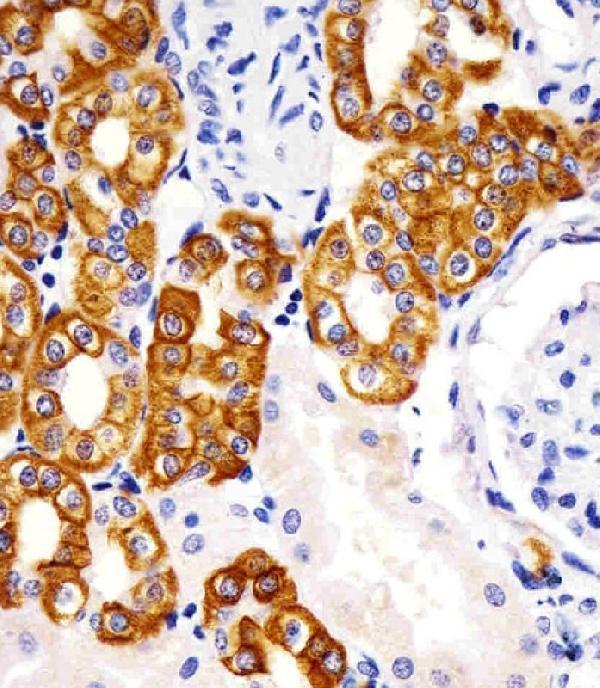
m02101 5 anti krt19 antibody ihc p testing 4

Product Info Summary
| SKU: | M02101-5 |
|---|---|
| Size: | 50 µl |
| Reactive Species: | Human |
| Host: | Mouse |
| Application: | IF, IHC-P, WB |
Customers Who Bought This Also Bought
Product info
Product Name
Anti-KRT19 Antibody
SKU/Catalog Number
M02101-5
Size
50 µl
Description
Boster Bio Anti-KRT19 Antibody (Catalog # M02101-5). Tested in IHC-P, IF, WB application(s). This antibody reacts with Human.
Storage & Handling
Maintain refrigerated at 2-8°C for up to 2 weeks. For long-term storage, store at -20°C in small aliquots to prevent freeze-thaw cycles.
Cite This Product
Anti-KRT19 Antibody (Boster Biological Technology, Pleasanton CA, USA, Catalog # M02101-5)
Host
Mouse
Contents
Purified monoclonal antibody supplied in PBS with 0.09% (W/V) sodium azide.
Clonality
Monoclonal
Clone Number
979CT14.3.1
Isotype
IgG1,k
Immunogen
This antibody is generated from a mouse immunized with a recombinant protein of human.
Reactive Species
M02101-5 is reactive to KRT19 in Human
Calculated molecular weight
44.1 kDa
Background of KRT19
Involved in the organization of myofibers. Together with KRT8, helps to link the contractile apparatus to dystrophin at the costameres of striated muscle.
Antibody Validation
Boster validates all antibodies on WB, IHC, ICC, Immunofluorescence, and ELISA with known positive control and negative samples to ensure specificity and high affinity, including thorough antibody incubations.
Application & Images
Applications
M02101-5 is guaranteed for IF, IHC-P, WB Boster Guarantee
Recommend Dilution
IF: 1:25
WB: 1:8000
IHC: 1:400
IHC-P: 1:25
Validation Images & Assay Conditions

Click image to see more details
Immunofluorescent analysis of 4% paraformaldehyde-fixed, 0.1% Triton X-100 permeabilized HepG2 (human liver hepatocellular carcinoma cell line) cells labeling KRT19 with M02101-5 at 1/25 dilution, followed by Dylight® 488-conjugated goat anti-mouse IgG secondary antibody at 1/200 dilution (green). Immunofluorescence image showing intermediate filaments staining on HepG2 cell line. The nuclear counter stain is DAPI (blue).

Click image to see more details
All lanes : Anti-KRT19 at 1:8000 dilution
Lane 1: HepG2 whole cell lysate
Lane 2: MCF-7 whole cell lysate
Lysates/proteins at 20 µg per lane.
Secondary
Goat Anti-mouse IgG, (H+L), Peroxidase conjugated at 1/10000 dilution.
Predicted band size : 44 kDa
Blocking/Dilution buffer: 5% NFDM/TBST.

Click image to see more details
Immunohistochemical analysis of paraffin-embedded Human Colon cancer section using Pink1. M02101-5 was diluted at 1:400 dilution. A undiluted biotinylated goat polyvalent antibody was used as the secondary, followed by DAB staining.
Click image to see more details
M02101-5 staining KRT19 in human kidney sections by Immunohistochemistry (IHC-P -paraformaldehyde-fixed, paraffin-embedded sections). Tissue was fixed with formaldehyde and blocked with 3% BSA for 0. 5 hour at room temperature; antigen retrieval was by heat mediation with a citrate buffer (pH6). Samples were incubated with primary antibody (1/25) for 1 hours at 37°C. A undiluted biotinylated goat polyvalent antibody was used as the secondary antibody.
Specific Publications For Anti-KRT19 Antibody (M02101-5)
Loading publications
Recommended Resources
Here are featured tools and databases that you might find useful.
- Boster's Pathways Library
- Protein Databases
- Bioscience Research Protocol Resources
- Data Processing & Analysis Software
- Photo Editing Software
- Scientific Literature Resources
- Research Paper Management Tools
- Molecular Biology Software
- Primer Design Tools
- Bioinformatics Tools
- Phylogenetic Tree Analysis
Customer Reviews
Have you used Anti-KRT19 Antibody?
Share your experimental results or join a short interview to earn up to $1,000 in product credits or other rewards.
0 Reviews For Anti-KRT19 Antibody
Customer Q&As
Have a question?
Find answers in Q&As, reviews.
Can't find your answer?
Submit your question




